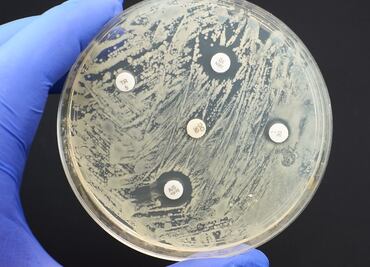

"Pandemia silenciosa": las infecciones por bacterias resistentes a antibióticos que matan a más personas que el sida
Más de 1,2 millones de personas murieron en solo un año en el mundo como consecuencia directa de bacterias resistentes a medicamentos antimicrobianos, según el estudio más amplio sobre el impacto de este fenómeno a nivel global




